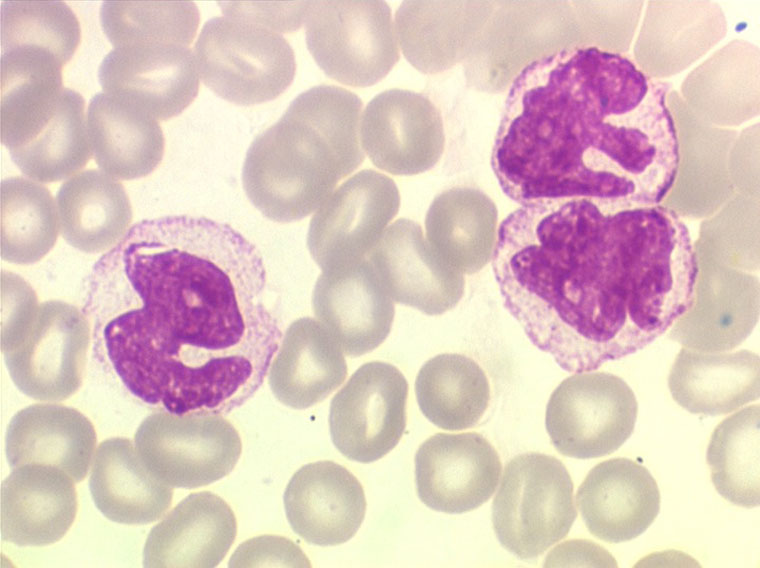

Моноцит 3 11
Вечером точно скажу сказал
Газовый котел fed напольный
Если болит живот чем обезболить
Песня катань
Кма область
Ultra 2 trail blue black
You re like that перевод
Данные рлс
Как доехать до жилмассива
Arcane style
Osman 186bölüm
Когда чищу уши хочется кашлять
Виды обязательств в праве
Моноцит 3 11 116 фото